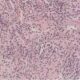
¿Qué es la Agranulocitosis?

Los estados aplásicos se refieren a condiciones médicas en las cuales hay una disminución significativa en la producción de células sanguíneas en la médula ósea. La médula ósea es el tejido esponjoso que se encuentra dentro de los huesos y es responsable de la formación de glóbulos rojos, glóbulos blancos y plaquetas. Cuando se produce una disminución drástica en la producción de estas células, se generan estados aplásicos, lo que puede tener consecuencias graves para la salud.
Anemia Aplásica y Embarazo
La anemia aplásica, una condición caracterizada por la disminución significativa en la producción de células sanguíneas en la médula ósea, puede diagnosticarse durante el embarazo. Incluso en algunos casos, mujeres que ya han sido diagnosticadas con anemia aplásica han quedado embarazadas después del diagnóstico. Sin embargo, el pronóstico en ambos escenarios es sombrío, y la mayoría de los casos mortales están asociados a complicaciones hemorrágicas.
En algunos casos singulares, mujeres que han tenido la fortuna de recuperar la función de la médula ósea después del parto, desarrollan anemia aplásica en un embarazo posterior. Esta peculiaridad plantea preguntas sobre la relación causal y la patogenia subyacente, ya que, hasta el momento, no se comprende completamente la conexión entre el embarazo y la anemia aplásica.
La falta de claridad en la patogenia y la relación causal entre el embarazo y la anemia aplásica sugiere la posibilidad de que estos eventos estén vinculados a un nivel elevado de activación inmunitaria durante el embarazo. Aunque los detalles precisos de cómo este fenómeno contribuye al desarrollo de la anemia aplásica no se conocen, se plantea la hipótesis de que la compleja interacción entre el sistema inmunológico materno y el feto pueda desencadenar respuestas inmunitarias que afecten negativamente la producción de células sanguíneas en la médula ósea.
Hemoglobinuria Paroxística Nocturna (HPN)
La hemoglobinuria paroxística nocturna (HPN) es una enfermedad adquirida que resulta de la expansión de un clon de células madre hematopoyéticas. Este clon, debido a una mutación somática inactivadora del gen PIGA, ubicado en el cromosoma X, da lugar a una descendencia de células incapaces de anclar proteínas esenciales en sus membranas.
El gen PIGA codifica una proteína crucial para la síntesis de glucosilfosfatidilinositol (GPI), que actúa como anclaje de membrana. La mutación en este gen conduce a la pérdida de la capacidad de anclar proteínas importantes como CD55 y CD59 a través de GPI. Estas proteínas son relevantes en las células normales para protegerlas del complemento activado, que es parte del sistema inmunitario.
La consecuencia directa de la pérdida de CD55 y CD59 es la hemólisis intravascular crónica y la predisposición a la trombosis. Sin estas proteínas ancladas a GPI, las células sanguíneas están más expuestas al ataque del sistema de complemento, lo que resulta en la destrucción de los glóbulos rojos y la formación de coágulos sanguíneos.
Es interesante destacar que la presencia de «clones HPN» no es infrecuente en pacientes con anemia aplásica adquirida. La evidencia experimental respalda la idea de que la evolución de las células madre con deficiencia del gen PIGA representa la selección de clones que resisten el ataque inmunitario. Este fenómeno sugiere una conexión entre la anemia aplásica y la HPN, con la aparición de clones resistentes como una respuesta adaptativa a la agresión inmunitaria.

Estados aplasicos causados por Síndromes Hereditarios de Insuficiencia de la Médula Ósea
Los estados aplasicos causados por síndromes hereditarios de insuficiencia de la médula ósea pueden manifestarse en la adolescencia y la edad adulta, y entre ellos destacan la disqueratosis congénita, la anemia de Fanconi y la anemia de Diamond-Blackfan. La investigación activa se centra en la comprensión de la patogenia molecular de la insuficiencia medular presente en estos procesos.
- Disqueratosis Congénita:
- En la disqueratosis congénita, las mutaciones afectan a genes que codifican proteínas y ARN implicados en el mantenimiento de los telómeros. Los telómeros son estructuras protectoras en los extremos de los cromosomas que se acortan con cada división celular. La disminución de la longitud de los telómeros está vinculada al envejecimiento celular y a la disfunción de las células madre. En este síndrome, las mutaciones afectan la capacidad de mantener la integridad de los telómeros, lo que puede llevar a la insuficiencia de la médula ósea.
- Anemia de Fanconi:
- En la anemia de Fanconi, las mutaciones afectan a las proteínas implicadas en la respuesta a la lesión del ADN. Este síndrome se caracteriza por la sensibilidad aumentada a la radiación y la propensión a desarrollar cáncer. Las células afectadas tienen dificultades para reparar el ADN dañado, lo que puede resultar en la pérdida progresiva de células de la médula ósea y la consiguiente insuficiencia medular.
- Anemia de Diamond-Blackfan:
- En la anemia de Diamond-Blackfan, las mutaciones inactivadoras afectan a proteínas ribosómicas con una participación conocida en la biogenia de los ribosomas. Los ribosomas son esenciales para la síntesis de proteínas. Las mutaciones en este síndrome afectan la producción normal de ribosomas, lo que puede conducir a una insuficiencia de la médula ósea y a la anemia.
Aunque la base genética de estos trastornos aplásicos ha sido bien definida en la última década, las funciones canónicas de las proteínas codificadas por estos genes son distintas para cada enfermedad. No está claro si la pérdida de estas funciones canónicas está directamente relacionada con la patogenia de la insuficiencia de la médula ósea en cada síndrome. La investigación continua busca comprender mejor estos mecanismos para desarrollar enfoques terapéuticos más precisos y efectivos.